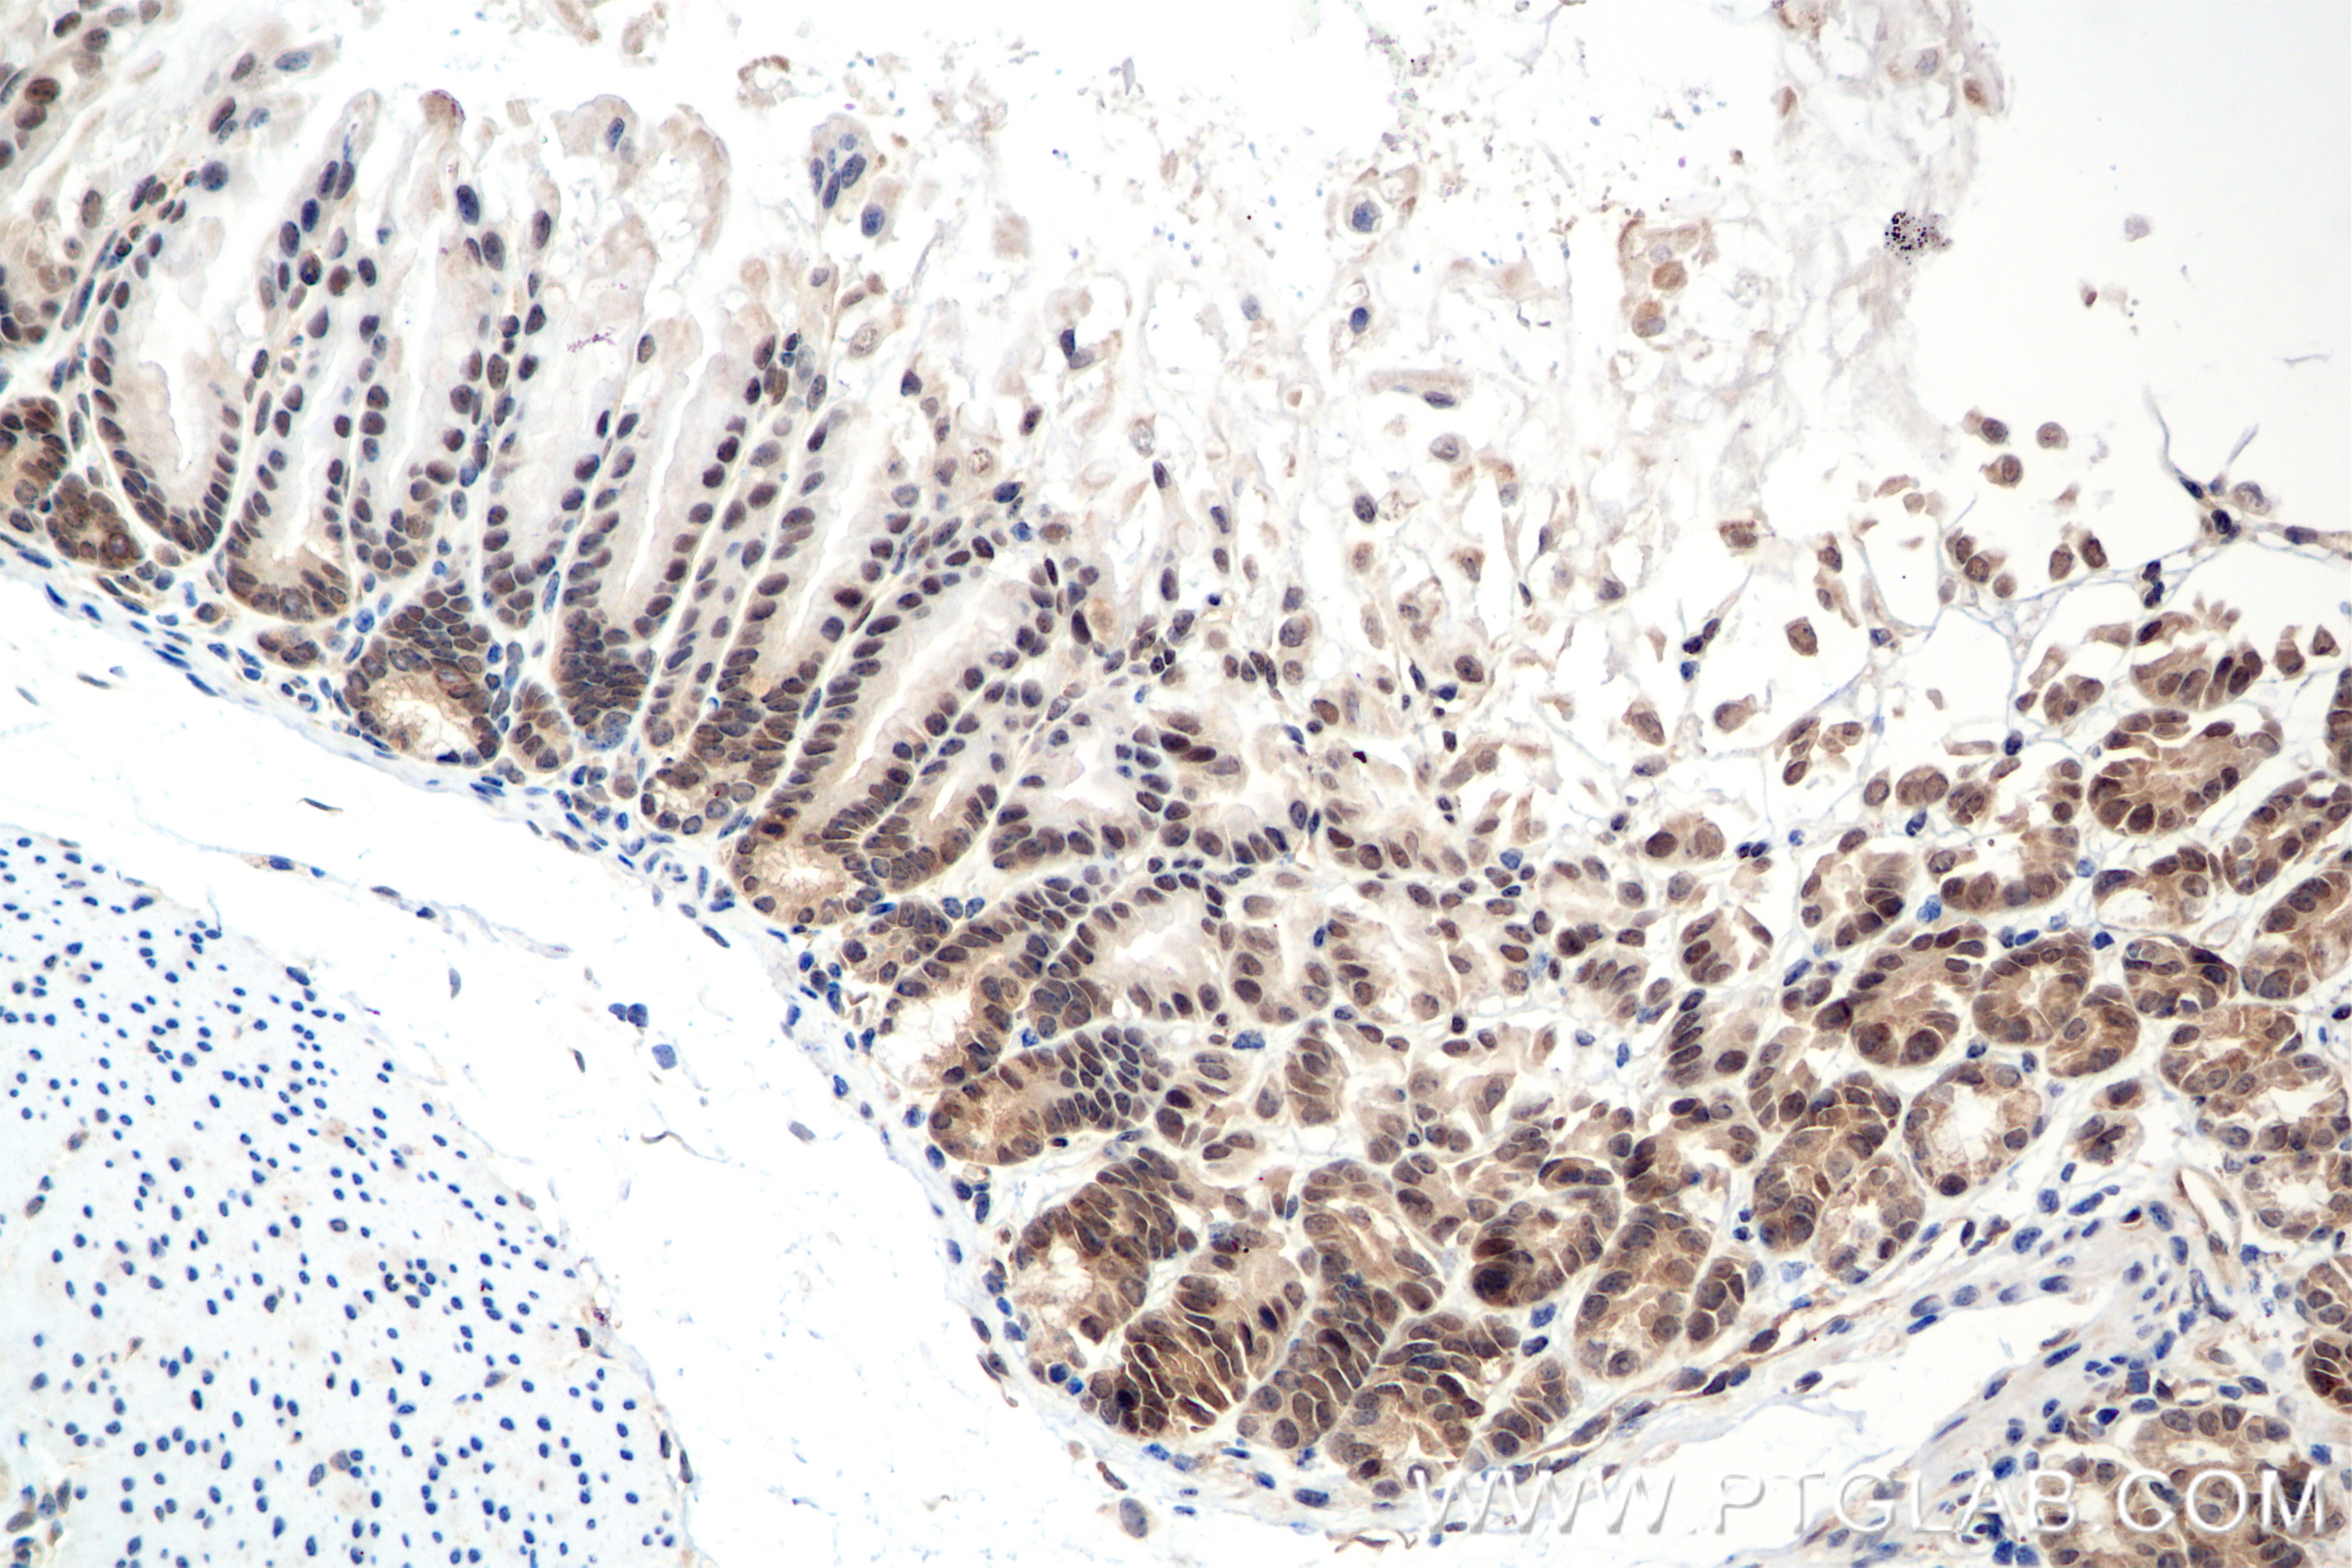
Immunohistochemical analysis of paraffin-embedded mouse stomach tissue slide using 85388-1-RR (SMAD1 antibody) at dilution of 1:500 (under 20x lens). Heat mediated antigen retrieval with Tris-EDTA buffer (pH 9.0). IHC staining of mouse stomach using 85388-1-RR

验证数据展示
经过测试的应用
| Positive WB detected in | HeLa cells, HepG2 cells, HEK-293 cells, HUVEC cells, HT-1080 cells, RAW264.7 cells, HSC-T6 cells |
| Positive IHC detected in | mouse stomach tissue Note: suggested antigen retrieval with TE buffer pH 9.0; (*) Alternatively, antigen retrieval may be performed with citrate buffer pH 6.0 |
| Positive FC (Intra) detected in | HeLa cells |
| Positive ChIP-qPCR detected in | BMP2 (50 ng/ml, 1 h) MCF-7 cells |
推荐稀释比
| 应用 | 推荐稀释比 |
|---|---|
| Western Blot (WB) | WB : 1:5000-1:50000 |
| Immunohistochemistry (IHC) | IHC : 1:250-1:1000 |
| Flow Cytometry (FC) (INTRA) | FC (INTRA) : 0.25 ug per 10^6 cells in a 100 µl suspension |
| CHIP-QPCR | CHIP-QPCR : 1:10-1:100 |
| It is recommended that this reagent should be titrated in each testing system to obtain optimal results. | |
| Sample-dependent, Check data in validation data gallery. | |
产品信息
85388-1-RR targets SMAD1 in WB, IHC, FC (Intra), ELISA, ChIP-qPCR applications and shows reactivity with human, mouse, rat samples.
| 经测试应用 | WB, IHC, FC (Intra), ELISA, ChIP-qPCR Application Description |
| 经测试反应性 | human, mouse, rat |
| 免疫原 |
CatNo: Ag0701 Product name: Recombinant human SMAD1 protein Source: e coli.-derived, PGEX-4T Tag: GST Domain: 19-229 aa of BC001878 Sequence: GWKQGDEEEKWAEKAVDALVKKLKKKKGAMEELEKALSCPGQPSNCVTIPRSLDGRLQVSHRKGLPHVIYCRVWRWPDLQSHHELKPLECCEFPFGSKQKEVCINPYHYKRVESPVLPPVLVPRHSEYNPQHSLLAQFRNLGQNEPHMPLNATFPDSFQQPNSHPFPHSPNSSYPNSPGSSSSTYPHSPTSSDPGSPFQMPADTPPPAYLP 种属同源性预测 |
| 宿主/亚型 | Rabbit / IgG |
| 抗体类别 | Recombinant |
| 产品类型 | Antibody |
| 全称 | SMAD family member 1 |
| 别名 | 242844B4, BSP1, BSP-1, hSMAD1, JV41 |
| 计算分子量 | 52 kDa |
| 观测分子量 | 55 kDa |
| GenBank蛋白编号 | BC001878 |
| 基因名称 | SMAD1 |
| Gene ID (NCBI) | 4086 |
| 偶联类型 | Unconjugated |
| 形式 | Liquid |
| 纯化方式 | Protein A purification |
| UNIPROT ID | Q15797 |
| 储存缓冲液 | PBS with 0.02% sodium azide and 50% glycerol, pH 7.3. |
| 储存条件 | Store at -20°C. Stable for one year after shipment. Aliquoting is unnecessary for -20oC storage. |
背景介绍
Transforming growth factor-β (TGF-β) superfamily is recognized as one of the largest families of secreted multifunctional peptides exerting different biological effects on a large variety of cell types, such as regulation of hormone secretion, stimulation of extracellular matrix formation, the inhibition of proliferation of many cell types, cell survival, bone formation, and chemotaxis for inflammatory cells. One of the most important proteins that modulate TGF-β ligand activity is the SMAD family proteins. SMAD1 is one of the receptor-activated Smads. It's also a signal transducers of BMP signaling and binds to several proteins involved in ubiquitin-proteasome system (UPS). Transcriptional modulator activated by BMP (bone morphogenetic proteins) type 1 receptor kinase.
实验方案
| Product Specific Protocols | |
|---|---|
| FC protocol for SMAD1 antibody 85388-1-RR | Download protocol |
| IHC protocol for SMAD1 antibody 85388-1-RR | Download protocol |
| WB protocol for SMAD1 antibody 85388-1-RR | Download protocol |
| Standard Protocols | |
|---|---|
| Click here to view our Standard Protocols |